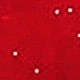
Red

SHEIN PETITE CURVE Plus Size Solid Color Starry Sky Drawstring Waist Straight Leg Casual Pants, Petite

SKU: sz25092819009951066
£13.49
Color:Green
Large Image

Size
0XL
1XL
2XL
3XL
4XL
Size Guide
Not your size? Tell me your size
Learn More
Shopping Security
Safe Payments
Privacy Protection
